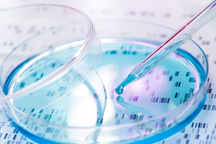
Phát minh công nghệ mới có thể lọc 99% hóa chất vĩnh cửu ra khỏi nước

Techfest Hải Phòng thu hút hơn 700 sản phẩm công nghệ, đổi mới sáng tạo
(Dân trí) - Hải Phòng đang trở thành một trong những địa phương có hoạt động khởi nghiệp đổi mới sáng tạo nổi bật nhất toàn quốc.

Gian hàng trưng bày, giới thiệu sản phẩm công nghệ tại Techfest Hải Phòng 2023 (Ảnh: Haiphong.gov).
Ngày 18/9, TP Hải Phòng tổ chức sự kiện Techfest Hải Phòng 2023. Đây là sự kiện thường niên của thành phố về lĩnh vực khoa học - công nghệ và đổi mới sáng tạo.
Phát biểu tại lễ khai mạc, Thứ trưởng Bộ Khoa học và Công nghệ Lê Xuân Định ghi nhận hệ sinh thái khởi nghiệp đổi mới sáng tạo của Hải Phòng đã và đang phát triển tương đối mạnh mẽ.
Những kết quả tích cực được Thứ trưởng nêu ra, gồm hỗ trợ gần 300 dự án, công ty khởi nghiệp đổi mới sáng tạo; xây dựng Đề án trung tâm hỗ trợ khởi nghiệp đổi mới sáng tạo của thành phố; tổ chức thành công nhiều sự kiện, cuộc thi về khởi nghiệp đổi mới sáng tạo...
Những điều này đã góp phần đưa Hải Phòng trở thành một trong những địa phương có hoạt động khởi nghiệp đổi mới sáng tạo nổi bật.
Theo Thứ trưởng Lê Xuân Định, thời gian tới, Hải Phòng không chỉ cần triển khai tốt, phát triển mạnh mẽ hoạt động đổi mới sáng tạo và khởi nghiệp của thành phố, mà phải trở thành trụ cột xây dựng hệ sinh thái đổi mới sáng tạo của Vùng Duyên hải Bắc bộ, Vùng đồng bằng sông Hồng, kết nối với các hệ sinh thái đổi mới sáng tạo quốc gia và quốc tế.

Thứ trưởng Bộ Khoa học và Công nghệ Lê Xuân Định phát biểu chỉ đạo tại Lễ khai mạc (Ảnh: Haiphong.gov).
Theo thống kê của ban tổ chức, từ năm 2017 đến nay, Techfest Hải Phòng đã có hơn 700 sản phẩm công nghệ đổi mới sáng tạo và sản phẩm khởi nghiệp sáng tạo tham gia trưng bày, đón tiếp khoảng 5.000 lượt đại biểu trong và ngoài nước tham quan, tham gia các hội thảo.
Bên cạnh đó, sự kiện bao gồm 6 cuộc thi khởi nghiệp, thu hút đông đảo các tổ chức, cá nhân tham gia, góp phần tạo bệ phóng vững chắc cho hàng chục doanh nghiệp khởi nghiệp đổi mới sáng tạo phát triển, lớn mạnh và gặt hái nhiều thành công.
Sau 7 năm triển khai kế hoạch phát triển hệ sinh thái khởi nghiệp đổi mới sáng tạo, hoạt động khởi nghiệp, đổi mới sáng tạo của TP Hải Phòng nhìn chung đã có sự chuyển mình mạnh mẽ và đạt được nhiều kết quả quan trọng.
Ở năm thứ 7 tổ chức, Techfest Hải Phòng được kỳ vọng sẽ tiếp tục thúc đẩy các giải pháp đổi mới sáng tạo trong lĩnh vực công nghệ số, nông nghiệp, tự động hóa, du lịch và ẩm thực...
Bên cạnh đó, các lĩnh vực "hot" như phát triển các nền tảng trực tuyến, thương mại điện tử, và mô hình kinh doanh mới cũng được chú trọng, nhằm hỗ trợ, tiếp cận thị trường, tạo đột phá thương mại hóa sản phẩm địa phương.
Techfest Hải Phòng 2023 diễn ra từ 18 đến 21/9, bao gồm các hoạt động trình diễn, trưng bày, giới thiệu và kết nối gần 500 sản phẩm công nghệ, 300 sản phẩm đổi mới sáng tạo, sản phẩm OCOP, sản phẩm chủ lực của thành phố với hơn 100 gian hàng.
Ngoài ra, còn có sự tham gia của đại sứ quán và chuyên gia đổi mới sáng tạo của một số nước: Hà Lan, Israel, Singapore, Hàn Quốc; các quỹ đầu tư, doanh nghiệp khởi nghiệp đổi mới sáng tạo trên địa bàn thành phố...